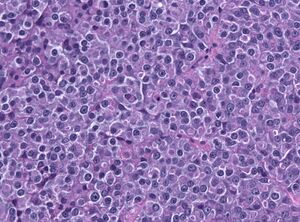

ورم پرولاكتيني (Q4897)
مرض يصيب الإنسان
| اللغة | التسمية | الوصف | أسماء أخرى |
|---|---|---|---|
| العربية | ورم پرولاكتيني |
مرض يصيب الإنسان |
|
| الإنجليزية | prolactinoma |
adenoma of the pituitary gland producing prolactin |
|
بيانات
Wikidata item الإنجليزية
OMIM ID الإنجليزية
subclass of الإنجليزية
health specialty الإنجليزية
instance of الإنجليزية
Commons category الإنجليزية
Freebase ID الإنجليزية
Encyclopædia Britannica Online ID الإنجليزية
MeSH descriptor ID الإنجليزية
eMedicine ID الإنجليزية
NCI Thesaurus ID الإنجليزية
exact match الإنجليزية
MeSH tree code الإنجليزية
drug or therapy used for treatment الإنجليزية
genetic association الإنجليزية
image الإنجليزية
وصلات الموقع
Marefa(١ مدخلات)
- marefa ورم پرولاكتيني
ويكيبيديا(٥ مدخلات)
- dewiki Prolaktinom
- enwiki Prolactinoma
- eswiki Prolactinoma
- frwiki Prolactinome
- hewiki פרולקטינומה